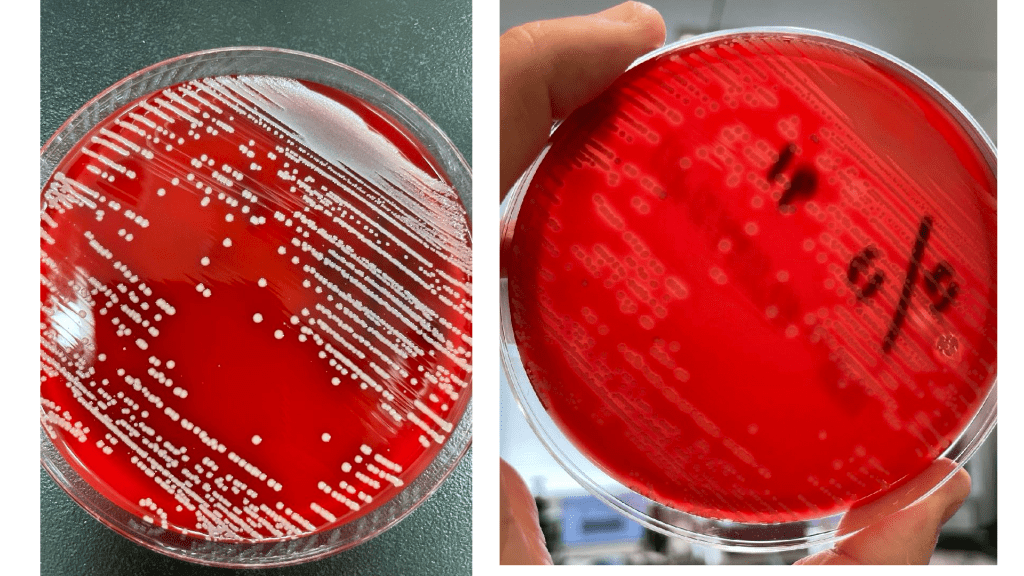
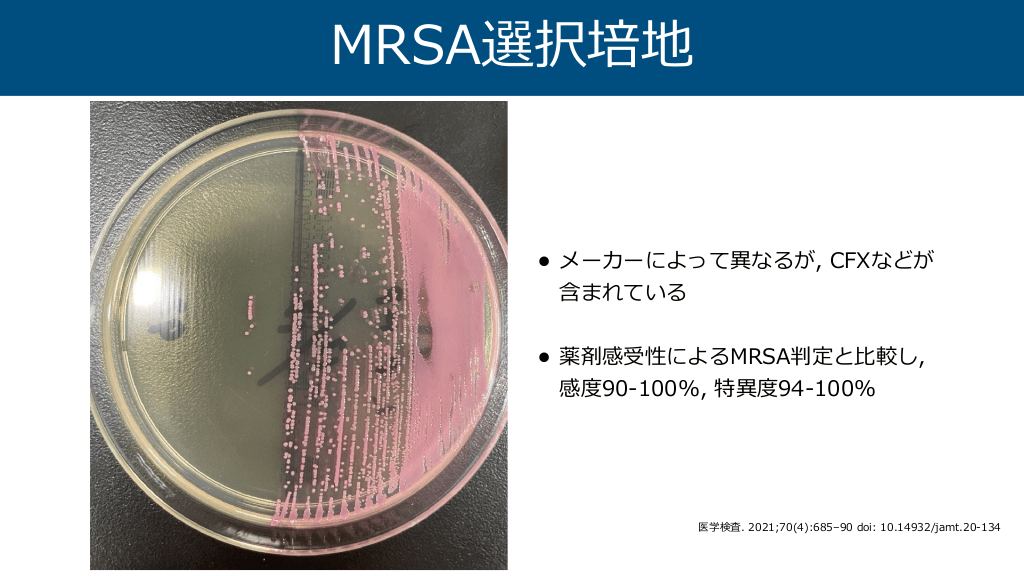
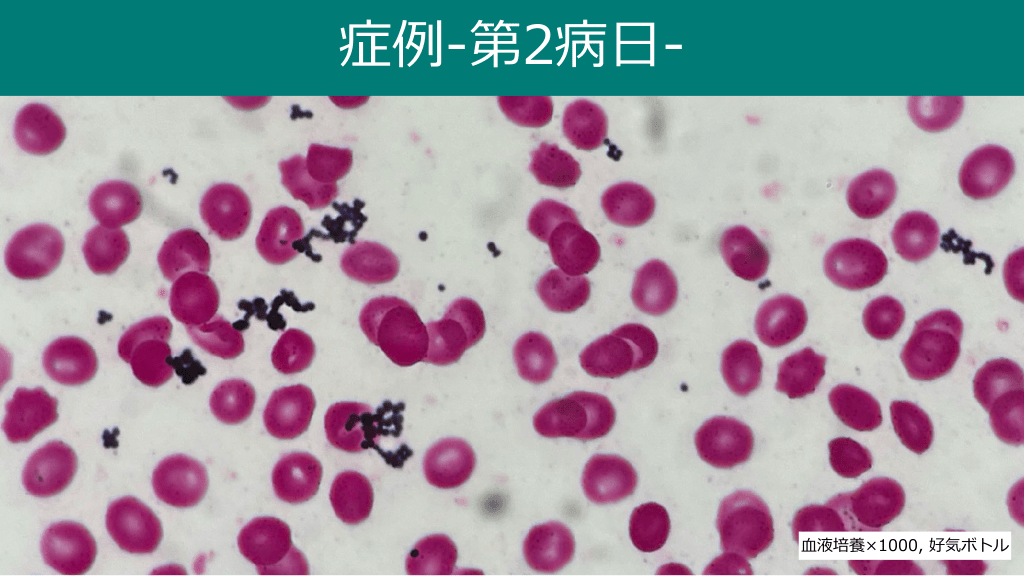
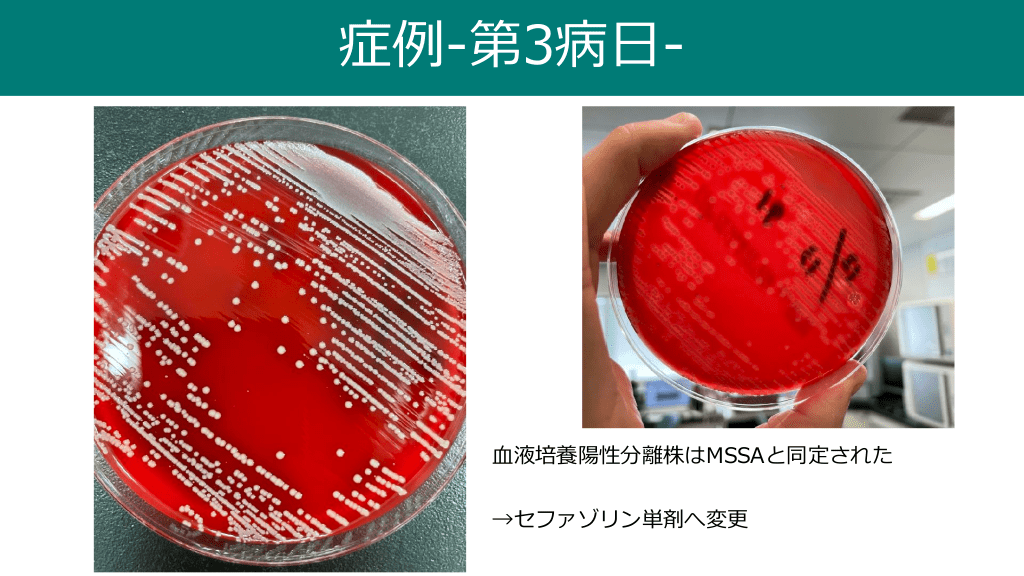

1/116
関連するスライド
診療に繋がるグラム染色
黒田浩一
260898
292
経口抗菌薬のエッセンス
高野哲史
382253
1052
感染症診療の基本的な考え方 -血液培養とその界隈-
高野哲史
45921
290
発熱性好中球減少症
長谷川耕平
80109
180
黄色ブドウ球菌菌血症の考え方
630,413
608
概要
院内勉強会で使ったレクチャースライドです。
以前のものをupdateして作成しました。
前半は黄色ブドウ球菌の感受性ごとの分類と各治療薬について、
後半は黄色ブドウ球菌菌血症の管理に関して根拠を踏まえつつまとめました。
だいぶ内容が濃くなってしまっていますが、興味があればぜひ。
本スライドの対象者
研修医/専攻医/専門医
投稿された先生へ質問や勉強になったポイントをコメントしてみましょう!
0 件のコメント
長谷川耕平さんの他の投稿スライド
細菌性髄膜炎のマネジメント
長谷川耕平
103,038
205
Mpox (サル痘) のまとめ (2023.04.19更新)
長谷川耕平
21,914
68
皮膚軟部組織感染症 overview
長谷川耕平
317,118
618
このスライドと同じ診療科のスライド
テキスト全文
黄色ブドウ球菌の基本情報と分類
#1.
2024.10.24 Staphylococcus aureusと SABと その周辺の話 谷 長 立 堺市 総合医療センター 感染症内科 川 耕平
#2.
目 次 • 分類 • 薬剤感受性試験とMRSA • 治療の原則 • 症例 2
#3.
• 運動性, 芽胞形成性, カタラーゼ陽性のグラム陽性球菌 (直径0.5-1.5 μm) • “Staphylococcus”とはギリシャ語の”staphylé”に由来し,“ブドウの房”という意味である • コアグラーゼ・クランピング因 の有無によりさらに分類される 子 Mandell, Douglas, and Bennett's Principles and Practice of Infectious Diseases, 194, 2393-2431.e9 非 非 Staphylococcus spp.
コアグラーゼ試験とその意義
#4.
コアグラーゼ クランピング因 S. aureus + + S. intermedius + d S. pseudintermedius + S. schleiferi subsp. coagulans + S. schleiferi subsp. schleiferi + S. lugdunensis + S. sciuri /+ S. epidermidis Manual of Clinical Microbiology, 11th Edition. Chapter 21 Staphylococcus, Micrococcus, and Other Catalase-Positive Cocci 子 生 −− −− − − − − 菌名 化学的性状
#5.
American Society For Microbiology ©
#6.
クランピング試験 — lCLINICAL MICROBIOLOGY PROCEDURES HANDBOOK3.17 BIOCHEMICAL TESTS FOR THE IDENTIFICATION OF AEROBIC BACTERIA 3.17.13 Coagulase Test Protein A/Clumping Factor Agglutination Method (Last updated:9 May 2023 )
薬剤感受性試験とMRSAの概要
#7.
• “aureus”はラテン語の”aurum”に由来し, “ • 通性嫌気性菌, • Enterotoxin (耐熱性), TSST-1, ET (SSSS), PVLなどの毒素を産 液寒天培地上でβ溶 する • や動物の • 膚軟部組織感染, 膚粘膜に常在 (健康成 の最 管内感染, 関節感染, ”を意味する がかったコロニーを形成する 30%が 前庭に保菌) 物感染を起こしやすい 肺炎は稀だが, インフルエンザ罹患後, VAP, 肺膿瘍 (塞栓由来) では起因菌となりうる Emerg Infect Dis. 2013;19(9):1553. Trends Microbiol. 2023;31(12):1300-1301. 生 鼻 工 色 人 金 黄 大 血 人 骨 血 Mandell, Douglas, and Bennett's Principles and Practice of Infectious Diseases, 194, 2393-2431.e9 血 • 皮 人 皮 Staphylococcus aureus
#9.
S. aureusと区別が難しい菌 • • 下記とS. aureusを合わせてS. aureus complexと呼ぶ - S. argenteus - S. schweitzeri - S. roterodami - S. singaporiensis ただし報告名はS. aureus complexで良く, メチシリン耐性株の感染対策もMRSAに準ず るため, 今のところ臨床的な差異はない1) Clin Microbiol Infect. 2019;25(9):1064-1070.
#10.
目 次 • 分類 • 薬剤感受性試験とMRSA • 治療の原則 • 症例 10
ペニシリン感受性の解釈と試験方法
#11.
薬剤感受性に基づく分類 • メチシリン耐性 色 ブドウ球菌 (MSSA) 色 メチシリン感受性 黄 • 黄 ブドウ球菌 (PSSA) 色 ペニシリン感受性 黄 • ブドウ球菌 (MRSA)
#12.
ペニシリン感受性 色 黄 PCN-MIC ≦ 0.12 ブドウ球菌 ?
#13.
ペニシリン感受性の解釈 CLSIでは, 微量液体希釈法やdisk法でペニシリン感受性となったStaphylococcus spp.に対し て, βラクタマーゼ産 の有無を確認するべきと記載されている CLSI. Performance Standards for Antimicrobial Susceptibility Testing. 34th ed. CLSI supplement M100. Clinical and Laboratory Standards Institute; 2024. 生 •
#14.
βラクタマーゼ確認試験 zone edge試験 • セフィナーゼ試験 • blaZ PCR (ペニシリナーゼをcodeする遺伝 子 • )
MRSAの定義とメチシリン耐性の判定
#15.
Zone edge test Fuzzy Sharp ペニシリナーゼ陰性 ペニシリナーゼ陽性
#16.
Zone edge test • PCN-MIC≦0.12μg/mLのうち, 6.9%がblaZ陽性である株に対するCLSI zone edge test (10-U PCN disk) の感度65.5%, 特異度99.8% (blaZ陽性がreference)1) • 低濃度PCN disk (1-U) を いたEUCAST zone edge testによるペニシリナーゼ検出の 感度・特異度は100%2) • 10-U PCN disk zone edge testによるペニシリナーゼ検出には限界がある → 治療失敗 の余地がない病態ではPCRによる確認が望ましい 用 1. J Clin Microbiol. 2016;54(3):812-814. 2. J Clin Microbiol. 2014;52(4):1136-1138.
#17.
セフィナーゼ試験 陽性 陰性 • 試薬によるβラクタマーゼの確認試験 • 誘導ニトロセフィン法 (PCN diskのedgeで施 35.5%1)と低いが特異度は い ) の感度は 行 高 1. J Clin Microbiol. 2016;54(3):812-814.
#18.
PCN-MICとペニシリナーゼの関係 • PCN ≦ 0.06なら3.8-6.2%のblaZ陽性株が存在, ≦0.03ならゼロ1-2) • 当院の 1. Clin Microbiol Infect. 2008;14(6):614-616. 2. J Clin Microbiol. 2016;54(3):812-814. 動感受性測定機器 (WalkAway ) ではPCN ≦ 0.12までしか測定できない 表 ペニシリン感受性のMSSA448株のblaZ PCR結果2)より作成 分離株内の検出数 (%) 分離株数 blaZ 陽性 blaZ 陰性 ≤0.015 1 0 (0) 1 (100) 0.03 24 0 (0) 24 (100) 0.06 370 14 (3.8) 356 (96.2) 0.12 53 17 (32.1) 36 (67.9) 計 448 31 (6.9) 417 (93.1) 自 ®︎ PCN-MIC (μg/ml)
#19.
blaZの発現について • blaR1とベータラクタムの相互作 によ り, repressorであるblaIが不活化し, blaZ がupregulateされる → 抗菌薬曝露によりPCN-Rになり得る 用 J Antimicrob Chemother. 2006;57(3):450-460.
#20.
MRSA 生 JANISは「MPIPCかCFXがRのS. aureus, または選択培地でMRSAと確認された菌」と定 義している ’ • 子 狭義にはmecA遺伝 を保有するSCCmec (Staphylococcal cassette chromosome mec) を染 体上に獲得することで, βLに親和性の低いPBP2 を産 しているS. aureus 色 •
SCCmecの種類とMRSAの疫学
#21.
メチシリン耐性の判定 1. 薬剤感受性 2. 選択培地 3. PBP2 の同定 方 子 ’ 4. mecA遺伝 の同定 法
#22.
薬剤感受性による判定 CLSI. Performance Standards for Antimicrobial Susceptibility Testing. 34th ed. CLSI supplement M100. Clinical and Laboratory Standards Institute; 2024.
#23.
− − − − 薬剤感受性による判定 Drug S. aureus S. lugdunensis Disk, mm (S, R) Oxacillin MIC, μg/mL (S, R) ≦2, ≧4 Cefoxitin ≧22, ≦21 ≦4, ≧8 Oxacillin ≧18, ≦17 ≦0.5, ≧1 Cefoxitin ≧25, ≦24 Oxacillin ≧18, ≦17 S. epidermidis S. pseudintermedius S. schleiferi Staphylococcus spp. 上記以外 Oxacillin Cefoxitin ≦0.5, ≧1 ≦0.5, ≧1 ≧25, ≦24 CLSI. Performance Standards for Antimicrobial Susceptibility Testing. 34th ed. CLSI supplement M100. Clinical and Laboratory Standards Institute; 2024.
#24.
MRSA選択培地 • メーカーによって異なるが, CFXなどが 含まれている • 薬剤感受性によるMRSA判定と 較し, 感度90-100%, 特異度94-100% 比 医学検査. 2021;70(4):685–90 doi: 10.14932/jamt.20-134
#25.
PBP2 検出イムノクロマト ’ モダンメディア. 2023;69(3):68-72
#26.
• 元々S. aureusが保有しているものではなく, Staphylococcus eurettiiに由来している という説が有 • S. eurettiiのmecAは細菌増殖と強く関連した染 • 体上に存在し, SCCmecとは関連なし 般流通している機器によるPCRが可能 fl 色 力 Antimicrob Agents Chemother. 2010;54(10):4352-4359. fl 一 mecA
#27.
SCCmec • mecA遺伝 (耐性に関与) と, ccrA, ccrB, ccrC遺伝 (可動性に関与) がkey • これらに加えて, 調節因 (mecR1, mecI) 及び調節因 を部分的に削除するinsertion sequenceの組み合わせにより13種類の SCCmecが確認されている 子 子 子 子 Drug Resist Updat. 2003;6(1):41-52. Methods Mol Biol. 2020;2069:59-78.
#28.
SCCmec SCCmecの推移@東京3) • MRSAは臨床的に院内型, 市中型と呼ばれることがあり, 最近学的にはSCCmecの型によって規定されている - typeⅠ-Ⅲ → 院内型, Ⅳ-Ⅵ→市中型 • “市中型”SCCmecの が, “院内型”よりもmolecular size が さく, 可動性が く, tness costが低い1) • ”院内型”は”市中型”と 較し, FQs耐性遺伝 をcocarriageすることが多いと われるが2), 実際は耐性株も 多い (特にUSA300) 1. Antimicrob Agents Chemother. 2007;51(4):1497-1499. 2. Mandell, Douglas, and Bennett's Principles and Practice of 子 言 fi 比 方 高 小 Infectious Diseases, 194, 2393-2431.e9 3. 環境感染誌. 2022;37(5):164-173 Antibiotic
#29.
• SCCmec Ⅳを保有するST8のMRSA (POT score:106-77-113) • PVL (Panton-Valentine leukocidin), ACME (arginine catabolic mobile element) 遺伝 (opp3AB, arcA) をcarrierし, 重症感染症を引き起こす • • 国では市中型MRSAの主流株 本では, PLWHでのUSA300アウトブレイク報告や, ψUSA300 clone (SCCmecのccrB2 に12塩基の 損), USA300-LV/J clone (USA300-LV cloneの類似株) など本邦で変異し た株も検出されている J Antimicrob Chemother. 2009;64(3):441-446. Emerg Infect Dis. 2015;21(11):1973-1980. J Infect Dis. 2021;223(4):610-620. 環境感染誌. 2022;37(5):164-173 欠 日 米 子 USA300
#30.
PVL陽性CA-MRSAの疫学@ 本 日 環境感染誌. 2022;37(5):164-173
MRSAの治療薬選択とその効果
#31.
院内型, 市中型MRSAの感受性 HA-MRSAの が, 全体的にMICが い (特にβラクタム) 比 高 環境感染誌. 2022;37(5):164-173 方 • 較
#32.
• MPIPC MICでスクリーニングする と, CLSIが定めるBP以下でも MRSAの可能性がある1) • ΔmecI, ΔmecR (class C mecA gene complex, Type Ⅴ) が, low-level MRSAと関連2-3) 1. 本臨床微 物学会雑誌. 2007;17(3):177-185 2. Antimicrob Agents Chemother. 2001;45(7):1955-1963. 3. Antibiotics (Basel). 2022;11(1):86. 生 日 Low-Level MRSA
#33.
“Stealth” MRSA • MPIPC, CFX両 に感受性を すが, PCRでmecA陽性となるS. aureus が存在する (つまり感受性だけ るとMSSA) • mecA遺伝 以外にSCCmec構造が全くないことが特徴で, 抗菌薬存在下 でmecAが発現する (MSSA→MRSAに変わる?) • mecA PCRが えない場合もMRSA選択培地で拾える可能性があり, また CFX disk di usionで阻 円内にコロニーを形成することで認知できる かもしれない 見 示 止 方 行 ff 子 Microbiol Spectr. 2022;10(3):e0029122.
#34.
PBP2 検出キットは偽陰性になるかも ’ Antimicrob Agents Chemother. 2019;63(8):e00558-19.
#35.
mecC • 2011年, UKにてウシからmecC陽性MRSAが検出されて以降, 欧州の野 ネズミ) から多く分離されるようになった1) • mecCはSCCmec XI内に存在し, 典型的にはセフォキシチン耐性, オキサシリン感受性と なる2) • 農村部に住む 動物 (特にハリ が感染するケースが多く3), 重症感染症をきたした報告もある4) 1. Sci Total Environ. 2022;815:152858. 2. J Antimicrob Chemother. 2023;78(5):1168-1174. 生 人 3. Clin Microbiol Infect. 2013;19(1):E16-E22. 4. J Antimicrob Chemother. 2014;69(1):45-50.
#36.
mecB • mecBは, 元々mecAmと われていたもので, 動物の 膚に寄 するMacrococcus caseolyticusのtransposon mec complex (Tn6045) にしばしば られるメチシリン耐 性遺伝 複合体の 部として報告された • CFXスクリーニングによって分離されたMRSAからmecB遺伝 が同定され, これはβラク タム調節遺伝 に隣接し, AGs (aacA-aphD, aphA, aadK), マクロライド (ermB), TC (tetS) に対する耐性もco-carriageした84.6kbのplasmidの 部である • 余談だが, mecD遺伝 がウシおよびイヌのM. caseolyticus分離株から検出された 見 生 子 一 皮 言 子 一 子 子 Emerg Infect Dis. 2018;24(2):242-248.
#37.
mec遺伝 以外のβラクタム耐性 • gdpP遺伝 ( 次メッセンジャーのc-di-AMPを加 分解する機能を持つGdpPをcode) 変異によ りβL感受性が低下するS. aureusが報告されており, modi ed methicillin-resistant Staphylococcus aureus (MODSA) と呼ばれる1-3) - gdpP関連変異はPDE機能の喪失を介して, MICの上昇は起こさずにβLへのtoleranceを上昇さ せ, PBP4変異と相乗的にβL耐性を付与するため, 抗菌薬曝露によるselectionにおいて有利3-4) • βラクタマーゼ過剰産 によりMPIPC低感受性 (1-8 μg/mL) となったものをBorderline oxacillin-resistant Staphylococcus aureus (BORSA) と呼ぶ (CFXは感受性)5-6) • その他, arcB (排出ポンプ), yjbH (ジスルフィドストレスエフェクター) などによるβL耐性が報 告されている3) fi 子 生 二 子 PDE, phosphodiesterase 水 1. J Antimicrob Chemother. 2019;74(5):1182-1191. 4. mBio. 2024;15(8):e0121024. 2. mBio. 2024;15(5):e0288923. 5. J Med Microbiol. 2017;66(10):1367-1373. 3. Antimicrob Agents Chemother. 2022;66(2):e0143121. 6. mBio. 2022;13(1):e0319621.
#38.
目 次 • 分類 • 薬剤感受性試験とMRSA • 治療の原則 • 症例 38
#39.
• • 適切な抗菌薬投与を う (原則的に点滴治療) 通り症状の問診・診察を う (特に 膚, 脊椎・関節, 腸腰筋, ) • 感染性 内膜炎/ 管内感染, 物周辺の所 は 々確認する (例:CA-SABの12%に IE合併1), primary focusが他にある 関節を有する患者の20%にPJIが発 2)) • よほどでない限り • 必ず • 可能な限りドレナージを う (ex. カテーテル抜去, 感染 症のclearanceを早め, 関連死亡を減らす3) エコーを う (CA-SAB, 液培養の陰性化を確認する (2-3 管内デバイス埋め込み後であれば必須) ごと) 物抜去, 膿瘍穿刺 etc) → 菌 生 音 心 工 人 日 血 見 日 工 皮 人 工 人 行 行 行 行 心 血 心 1. Open Forum Infect Dis. 2022;9(12):ofac647. 2. Open Forum Infect Dis. 2019;6(6):ofz218. 3. Clin Infect Dis. 2020;70:566-573. 血 一 血 SAB治療の原則
#40.
治療薬選択 (MSSA) • セファゾリン • 抗 本では単独使 • ペニシリン (PSSAの場合) • その他 用 Anti-Staphylococcal Penicillins:ASPs 日 色 黄 - ブドウ球菌ペニシリン ( 不可)
抗MRSA薬の各臓器への移行性
#41.
CEZ vs ASPs • 後ろ向きコホート研究@フランス • MSSA-IE (Duke sで定義) に対して, CEZとASPsは同等 (aOR 1.2; 95% CI 0.49-2.91) • 有害事象による抗菌薬変更はASPsで多い (0% vs 8%)。 • 原因は, 腎機能障害(61%)> 疹(23%)> 球減少(15%)>消化器症状(8%) 血 皮 ’ Clin Microbiol Infect. 2021;27(7):1015-1021.
#42.
CEZ vs ASPs 死亡率 再燃率 • 19の研究 (13,390名) を対象としたメタ解析 • CEZの使 は, 全死亡率低下 (OR 0.71, 95% CI 0.56–0.91), 臨床的失敗減少 (0.55, 0.41– 0.74), 有害事象による抗菌薬中 の減少 (0.25, 0.16–0.39) と関連 • しかし, 感染再発はCEZ患者で多い (1.41, 1.04–1.93) • 患者数の多い研究結果にかなり影響されている 止 用 Infect Dis Ther. 2019;8(4):671-686.
#43.
CEZ vs PCG/ABPC • PSSABに対するCEZ vs PCG/ABPCを 較した, 単施設後ろ向き観察研究@ • PCG MIC≦0.03 mg/Lの場合, PSSAと定義 (zone edgeやblaZ PCRは未施 • 44 • PCNs vs CEZ:IE 0 (0%) vs 3 (9.1%), CRBSI 1 (9.1%) vs 14 (42.4%) • 有害事象や菌 がinclusion criteriaを満たし, 11 本 ) がPCNs (n=3 PCG, n=8 ABPC) 症の再燃は有意差なし → PCNsでPSSABは治療可能 行 日 人 比 血 人 J Infect Chemother. 2020;26(4):358-362.
#44.
• 複数の観察研究において, CTRXによるtargeted therapyを 失敗が増加すると報告されている1-2) • MSSAをCTRXで殺菌するためには, 1回2g 1 2回が必要であり, 腎機能が正常だと 適 中濃度に到達しない3) • ただし, 重篤かつIEなどのcomplicated SABでなければ, CTRXはOPATに使える可能性 がある4-6) われたSABはCEZより治療 Open Forum Infect Dis. 2018;5(5):ofy089. Eur J Clin Microbiol Infect Dis. 2023;42(4):423-430. Int J Antimicrob Agents. 2022;59(3):106537. Open Forum Infect Dis. 2020;7(9):ofaa341. Antibiotics (Basel). 2022;11(3):375. Open Forum Infect Dis. 2024;11(2):ofad662. 至 行 日 1. 2. 3. 4. 5. 6. 非 血 CEZ vs CTRX
#45.
CEZ vs others • PS matchを いてMSSABに対するASPs, CEZ, PTZ, FQ (LVFX or MFLX) を評価した 後ろ向きコホート研究@英国 • 30 • nafcillin/oxacillinとCEZを 較すると変わらず • nafcillin/oxacillin/CEZはPTZと 較すると, 30 0.01-0.78) • FQとβLは変わらず (HR 1.33, 95% CI 0.30-5.96) 死亡率, 退院までの時間, 院内死亡, 30 再 院, 30 以内のMSSABの再燃を評価 死亡率が低かった (HR 0.10, 95%CI 日 入 日 日 比 比 用 日 Open Forum Infect Dis. 2019;6(7):ofz270.
#46.
Inoculum e ect (InE) • 菌量 (inoculum) が増えたときに抗菌薬が効きにくくなること • MSSA株の中で, MEPM 0.0%, CFPM 0.3%, CTRX 2.3%, PTZ 43.0%, SAM 65.9%とβL/βLI で多い • A-Dのうち, Type C blaZのInEが強い (non-Type C vs Type C:S/A 45% vs 93%, T/P 9% vs 88%) ff Eur J Clin Microbiol Infect Dis. 2019;38(1):67-74.
#47.
InE for CEZ • CEZによる治療が失敗したMSSAB株半数にInEが確認された (107 CFU/mlでCEZ MIC≧ 16 μg/ml) が治療成功例にはInEを認めず1), CEZ InEを持つ株による菌 症はCEZ治療 群での30 死亡率を含めた治療失敗と関連している可能性がある2-3) • 北 では, 臨床分離株の最 25%にCEZ InE (type C 53.7%, type A 44.4%) が確認さ れており3), 臨床転機の悪化と繋がるというエビデンスが多いわけではないが, 今後の動 向を注視する必要がある。 い菌量を減らすことが重要 Antimicrob Agents Chemother. 2009;53(8):3437-3441. Open Forum Infect Dis. 2018;5(6):ofy123. Clin Microbiol Infect. 2018;24(2):152-158. J Clin Microbiol. 2022;60(7):e0249521. 血 行 大 日 米 → 可能な限りドレナージを 1. 2. 3. 4.
#48.
治療薬選択 (MRSA) • グリコペプチド • ダプトマイシン • オキサゾリジノン • その他
#49.
主要な抗MRSA薬の 各臓器への移 性 行 Clin Microbiol Infect. Published online August 27, 2024. doi:10.1016/j.cmi.2024.08.021
#50.
治療薬選択 (MRSAB) • DAP, LZD, およびCFTなど, MRSAに対して活性を有する他の薬剤がいくつかあるが, こ れらのいずれもRCTにおいてもVCMより優れたものはなかった1-3) • TEICは, SRでVCMと臨床的治癒は同等とされているが4), 疣贅への効果が乏しい可能性が 指摘されている5) 1. 2. 3. 4. 5. Semin Respir Crit Care Med. 2015;36:17-30. N Engl J Med. 2006; 355: 653-665 J Antimicrob Chemother. 2005; 56: 923-929 Cochrane Database Syst Rev. 2010;(6):CD007022. J Infect Dis. 1989;159(5):938-944.
複雑性SABの治療と管理方法
#51.
治療薬選択 (MRSAB) • DAP (6 mg/kg) は, RCT1)においてVCMに 劣性だが, MRSAB患者64例のみが参加し, DAP治療に失敗した患者の約1/3から分離された株は, DAP感受性の急激な悪化あり • CFTは, 観察研究において治療失敗率がIE (30%) および細菌性肺炎 (28%) で が2), DAPとの 較試験 (IE 30%) では治療失敗率について 劣勢だった3) かった → 現時点ではMRSABに対する第 選択薬はVCMを推奨 1. N Engl J Med. 2006; 355: 653-665 2. Antimicrob Agents Chemother. 2014; 58: 2541-2546 高 非 非 一 比 3. Open Forum Infect Dis. 2021;9(3):ofab606.
#52.
VCMは2023年で65周年になるため, ぼちぼち引退の声が上がっている • 中濃度の ち上がりがDAPやβLと 較し悪いこと, て, DAP群で30 死亡率が低いことなどがその理由 • “Those who cite registrational trials showing newer drugs like daptomycin or ceftaroline to be noninferior to vancomycin as a justi cation that we have yet to show there are better treatments are o target.” と述べつつ, 質の いRCTが必要と 結論づけている 量DAPとVCMの観察研究におい 高 fi 用 高 ff 比 日 Open Forum Infect Dis. 2022;9(5):ofac137. 立 血 •
#53.
VCM • グリコペプチド系抗菌薬 • 細胞壁を構成するムレインモノマー末端のD-alanyl-D-alanineに結合し細胞壁の合成を阻害 • MRSAに対して, AUC/MIC 400-600を 標にトラフ&ピークを測定する (MIC1μg/mL設定) • 副作 :infusion reaction, 腎機能障害 (尿細管), 球減少, 難聴 - infusion reactionの予防:1g/hより遅い速度で投与, 抗ヒスタミン薬を前投与する - 腎機能障害の予防:濃度測定, NSAIDs/AGsなどとの併 昇するが, シスタチンCは上昇しない) を避ける (PTZとの併 はCre上 用 用 血 目 用 抗菌薬TDM臨床実践ガイドライン2022 Intensive Care Med. 2022;48(9):1144-1155.
#54.
• ホスファチジルグリセオールを介して細胞膜と結合し, Ca2+依存性に細胞膜へ挿 され, 脱分極を起こしK+, Mg2+, ATPなどを細胞から排出させることで抗菌作 を発揮する • バイオフィルムへの活性や, • 肺サーファクタントで不活化されるため, 肺炎には • • 芽細胞内への活性がある いることができない 量依存性に横紋筋融解症を起こす可能性があり, 好酸球性肺炎をきたす症例もある 好酸球性肺炎発症までの中央値19-26 , リスク因 は70才以上, 21 量, 透析であり, 呼吸器症状やEo≧5%となれば注意が必要 以上投与, 男性, J Antimicrob Chemother. 2018;73(1):1-11. Infection. Published online July 19, 2024. doi:10.1007/s15010-024-02349-z 入 用 日 用 子 日 骨 Open Forum Infect Dis. 2022;9(4):ofac065. 用 用 高 DAP
#55.
• 50Sリボゾームサブユニットと結合し, 蛋 • 中枢移 • 副作 として, ミトコンドリア機能不全を介した 球減少があり2), 2週間程度で起こりう る3)。その他, MAO阻害効果を介したSSRIとの併 によるセロトニン症候群4), 消化器症 状, 味覚障害, 乳酸アシドーシス, 末梢神経障害などが挙げられる • MRSA肺炎やSSTIについて, LZDはVCMよりも臨床的治癒率が • 疣贅内のMRSAに対して 分な効果を発揮するためには, 50-75mg/kg必要7)なので初期 治療としては不適当 合成を阻害する は悪い1) い可能性がある5-6) 5. Clin Infect Dis. 2012;54(5):621-629. 2024. doi:10.1128/aac.00533-24 3. Canadian Journal of Infectious Diseases. 2001;12(6):379-390. 6. Cochrane Database Syst Rev. 2016;2016(1):CD008056. 7. Antimicrob Agents Chemother. 2001;45(8):2304-2308. 高 2. Antimicrob Agents Chemother. Published online September 19, 用 4. Antimicrob Agents Chemother. 2014;58(12):7198-7204. 血 1. JAC Antimicrob Resist. 2021;3(1):dlaa114. 白 行 性は良好だが, 尿への移 十 行 用 LZD
#56.
TZD LZDとの 較 比 J-IDEO. 2023;7(4):592-595
#57.
用 治療薬選択 (others) • FQs • TMP/SMX • CLDM • TCs (MINO, DOXY) • 併 療法
#58.
• CLSIに”Staphylococcus spp.はFQsによる治療中に数 • FQs耐性は, ①排出ポンプ (NorA), ②作 部位変異 (topoisomerase IV, gyrase) の2つの機序に よって じ, stepwise式にMICが上昇する1) • IEのanimal modelにおいて, CPFX 750mg×2は耐性株が じたが, LVFX 350mgでは認めず2), LVFXは耐性株の選択性が低い可能性がある。しかし, 低濃度のFQsに暴露したS. aureusは, DOXYやCLDMなど他クラスの抗菌薬に対して耐性を獲得する可能性が指摘されている3) • で, Staphylococcus spp.による 関節感染にはLVFX+RFPが推奨されており4), 適応を考 えて使 することが重要 (他に選択肢があるため菌 症で いることは無い) で耐性化する可能性がある”と記載あり 1. Antimicrob Agents Chemother. 1997;41(12):2733-2737. 生 用 日 血 用 工 人 生 用 2. Antimicrob Agents Chemother. 1997;41(8):1662-1667. 3. PLoS One. 2023;18(7):e0287973. 4. Clin Infect Dis. 2023;77(7):e34-e45. 方 一 FQs
#59.
• • 複雑性 • 膚軟部組織感染症・ 下膿瘍では選択しやすい1-2) 菌 症を含む重症MRSA感染症のRCTにおいて, バンコマイシンに対する きなかったが3), 内服スイッチ先として使える可能性がある4) • 量はTMP/SMX 160/800mg 1 使 2回 (SSTIについては 量と 劣性を証明で 較し差なし)5) 中のSCVs (small colony variants) の出現が問題となることがある 1. Lancet. 2014;384(9960):2132-2140. 2. N Engl J Med. 2016;374(9):823-832. 3. BMJ. 2015; 350: h2219 非 比 用 高 日 皮 皮 血 4. Lancet Infect Dis. 2024;24(5):523-534. 5. Antimicrob Agents Chemother. 2011;55(12):5430-5432. 用 非 用 TMP/SMX
#60.
• 菌 症に対する初期治療で 薬として選択しやすい1-3) • 規模なRCTでは, 重症S. aureus感染 (NSTIは除く) に対するCLDM追加は, 14 アウトカムを改善しないことがわかった4) • 現在, • CLDMはCD腸炎リスクが他抗菌薬と いることはないが, TMP/SMXと同様にSSTIやPJIの経 以内の く6), 使 中の下痢には注意が必要 1. 2. 3. 4. 5. 6. Clin Infect Dis. 2011;52(3):e18-e55. N Engl J Med. 2017;376(26):2545-2555. N Engl J Med. 2015;372(12):1093-1103. JAC Antimicrob Resist. 2022;4(1):dlac014. Trials. 2023;24(1):795. Int J Antimicrob Agents. 2024;64(4):107288. 口 較し 用 高 比 行 用 大 治療 われている (SNAP trial)5) 日 規模なplat form RCTが 60 血 小 CLDM
症例紹介とSABの診断基準
#61.
TCs (MINO, DOXY) • MINOやDOXYは, 後 視的研究においてMRSA SSTIに対する有効性が確認されており1), ガイドラインでもSSTIやPJIの経 選択肢に っている (TMP/SMX, CLDM同様)2) • リボソーム保護蛋 • しかし, 排出ポンプをcodeするtet(K)遺伝 を保有している場合はDOXYは誘導耐性が じる , MINOには影響がない4) • そのような理由と, 経験上からMRSA感染に対してTCsを を推奨する意 もある5) をcodeするtet(M)遺伝 によりMINOとDOXYは耐性化する3) 1. 2. 3. 4. 5. Antimicrob Agents Chemother. 2007;51(9):3298-3303. Clin Infect Dis. 2011;52(3):e18-e55. Antimicrob Agents Chemother. 1990;34(8):1611-1614. Clin Infect Dis. 2009;48(10):1483-1484. Int J Antimicrob Agents. 2010;35(5):517-518. 生 用 入 子 子 口 方 白 見 方 一 61 いる場合, DOXYよりもMINO
#62.
SABに対する併 治療 • MSSABに対してCEZとETPを併 すると, CEZ単剤と 較し菌 る可能性がある1) - 症のクリアランスが早くな カルバペネムがPBP1に結合することで, CEZと相乗的に作 する • MRSABに対するDAP+CFTは標準的治療と 0.06-0.89)2) • MRSABに対して, DAP+FOSはDAP単剤と 較し治療成功率が い傾向にある (54.1% vs 42.0%; RR, 1.29 [95%CI, .93-1.8]; P = .135)3) • MRSABに対するVCM+BLは転機や菌 症のクリアランスを改善せず, 腎機能障害増加4) 較し治療失敗率が下がる (OR 0.23, 95%CI 1. 2. 3. 4. 高 血 用 比 比 比 用 血 用 ETP, ertapenem; CFT, ceftaroline; FOS, fosfomycin Clin Infect Dis. 2020;71(6):1413-1418. Int J Antimicrob Agents. 2021;57(4):106310. Clin Infect Dis. 2021;72(9):1517-1525. JAMA. 2020;323(6):527-537.
#63.
• SABに対するRFP追加 (2週間) が治療失敗や再 発, 死亡に影響するか評価したRCT (MRSAは6%) • 弁または 管内 • 関節 (プラセボ1%, RFP2%), 物 (プラセボ6%, RFP4%) 転機:治療失敗や死亡は不変, 菌 症の期間も短 くならないが, deep tissue infectionの再燃は減 るかも → SABに対するroutineのRFP追加は不要 血 工 人 fi 工 人 fi Lancet. 2018;391(10121):668-678. 工 人 血 CEZ + RFP for MSSAB bacteriologically con rmed treatment failure or disease recurrence, or death, (A), clinically de ned treatment failure or disease recurrence, or death, (C), and mortality (D) from randomisation to 12 weeks
#64.
DAP+CEZ for MRSAB • DAPとCEZを併 すると, MRSAのDAP-MICが下がる1) • βLが細胞表 • DAP+βLはMRSABの転機を改善する可能性がある3) の陽性荷電を減少させることで, DAPの細胞膜への結合を強化する2) 用 面 1. Antimicrob Agents Chemother. 2016;60(7):3970-3975. 2. Clin Infect Dis. 2011;53(2):158-163. 3. Clin Infect Dis. 2020;71(1):1-10.
#65.
Clin Infect Dis. 2021;73(12):2353-2360.
#66.
SABのoral switchは条件次第で可能かも • 成 - のuncomplicated SABに対するoral switchについて評価したRCT 除外基準は厳しい:深部感染症 (e.g., IE, 肺炎, 物感染, ドレナージされていない膿瘍, 膿胸, 髄炎), ランダム化前4 以内のseptic shock, 治療開始後72時間以降の 培持続, ランダム化前2 以 内に>38°Cが2 以上あった場合, index cultureから4 以内に 管内カテーテル抜去なし, SAB関連 合併症 リスク (過去3ヵ 以内のSAB既往, IVDU, 重度免疫不全, 臓弁や深在性 管など) • IV5-7 • MSSA/MRSAに対しTMP-SMX 160/800mg q12, MSSAに対しCLDM 600mg q8h, MRSAに対しLZD 600mg q12h • 転機:90 以内のSAB関連複合転機 (SAB再燃, S. aureusによる深部感染, SAB関連の死亡) は両群有意 差なし (PO 13% vs IV 12%, 95% CI -7.8 to 9.1), PO群の が退院が早い傾向 (12d vs 16d, 95% CI -7.5 to 1.4) のあと, IV or POにランダム化し, total 14 間となるよう治療 骨 日 血 工 人 心 血 工 人 血 方 日 日 工 人 月 日 日 日 高 日 人 Lancet Infect Dis. 2024;24(5):523-534.
#67.
• 諸外国ではMSSAB+CNS感染合併の場合でも, ASPsを にならない • 本ではそれがないため, CEZで治療を続けるか, CTRX or CTXへスイッチするか, CEZ+CTRXにするかなど施設間で様々なことがされている (答えはない) • 髄膜炎・脳膿瘍以外に, 脳出 では脳表からの培養が陽性となると われているが1), 梗塞, 未破裂動脈瘤がある場合に中枢移 性を気にするべきかもunresolved issue • 個 的には後者 いることができるため特に問題 つではあまり気にしていない 小 言 用 行 血 二 1. Stroke. 1972;3(2):117-122. 人 日 MSSAB+中枢神経合併症
#68.
CEZに中枢移 性はあるのか? • セファロチン (1st GC) は 炎症性CSFへの移 が悪く, 肺炎球菌肺炎に対しセファロチ ンを投与された患者で肺炎球菌髄膜炎が じた, といった経緯もあり, 同classのCEZは中 枢感染に使 されなくなった1) • MSSA髄膜炎に対するCEZ 8g or MCIPC 12gの持続点滴は, CEZの CSF/MIC が く, MCIPC群でのみ治療失敗があった2) • CEZ 2g q8hでもCNSドレーンから採取された髄液中にCEZが検出可能3) • 最近のreviewでは, SAB+中枢病変合併時の治療選択肢としてCEZも考慮するよう記載さ れており4), 今後の臨床データ次第でマネジメントが変わるかもしれない 漿 及び 比 Clin Microbiol Infect. 2020;26(2):258-259. Clin Microbiol Infect. 2020;26(10):1415.e1-1415.e4. Open Forum Infect Dis. 2021;9(2):ofab649. Am J Med. 2023;136(1):19-26. 血 方 行 生 行 非 高 用 比 1. 2. 3. 4. がCSF/
#69.
目 次 • 分類 • 薬剤感受性試験とMRSA • 治療の原則 • 症例 69
#70.
57歳男性, 3 前からの発熱で, 救急外来を受診 • 無職, 独居, 期にわたるアルコールの 量摂取歴あり • 定期的に近医でビタミン剤の点滴を受けている。 • 常 • 最近の 薬はなく, 薬物アレルギーもない。 術, 外傷なし。 大 日 • 長 手 用 症例
SABの治療期間と管理の重要性
#71.
• 体温40.1℃, HR 100 bpm (reg/reg), BP 140/90 mmHg • 70 kg, 診察上明らかな感染巣はなし。 • なく正, 出 斑なし 液検査:Plt 9.5×103/μml, Alb 3.0 g/L, AST 120 IU/ml, ALT 70 IU/ml, ビリルビ ンおよび腎機能, プロトロンビン時間は正常。 • CRP 15 mg/dL 入 日 目 液培養採取し, 熱源精査 血 音 雑 • → 血 心 血 症例-第1病 - 的で 院
#72.
液培養×1000, 好気ボトル 日 血 症例-第2病 -
#73.
MALDI-TOF MSで Staphylococcus aureusと同定された *S. aureusはMALDI-TOF MSを いてほぼほぼ正確に同定可能1) 用 1. Front Cell Infect Microbiol. 2021;11:632679.
#74.
1. 点滴や外傷, 術などエントリーとなる部位はないか? 2. フォーカス形成していないか?疼痛が出現した部位はないか? 3. 物は埋め込まれていないか? 心 食 手 4. IEはどうか?経 道 工 人 SAB患者でまず検討すべきこと エコーは実施するべきか?
#75.
Staphylococcus aureus bacteremia, SAB • GPC clusterが1setでも 液培養から検出された場合, まずは臨床的にS. aureusが うる状況かを考える (ex. 熱源不明, 物, etc) • もしMRSAの有病率がSABエピソードの>25% (全患者), または>10% (敗 あればMRSAも標的として治療を う1) え 症患者) で 生 血 工 人 行 血 1. JAMA. 2016; 315: 801-810
#76.
1セットだけS. aureusが発育したとき • S. aureusが ある1-2) • ただし, 液培養1setのみで検出されたとき, コンタミネーションの可能性が1-10% 液培養1セットのみ陽性であっても, IEの可能性が約4%ある2) 基本的には真の菌 症として治療するべき 1. Am J Med. 2010;123(9):819-828. 血 血 血 2. Open Forum Infect Dis. 2021;9(2):ofab642.
#77.
SABはエントリー不明が40% Clin Infect Dis. 2000;31(5):1170-1174.
#78.
Variables P OR (95% CI) 固形腫瘍 <0.001 3.95 (2.02–7.72) 慢性腎臓病 <0.001 4.03 (1.92–8.44) 中 <0.001 3.69 (2.15–6.34) <0.001 3.79 (2.20–6.51) 0.004 2.25 (1.30–3.88) 表. situation別SABリスク1) 院 ≥48 h 静脈カテーテル 以前の 院 以前の抗菌薬使 院 <48 h 期療養施設 0.04 6.61 (1.02–42.89) 0.007 5.67 (1.61–19.98) CCI≥3 0.01 4.98 (1.38–18.07) ステロイド治療中 0.02 4.78 (1.26–18.12) 0.008 6.21 (1.62–23.77) HIV 0.01 11.03 (1.79–67.76) 慢性肝疾患 0.01 6.00 (1.54–23.37) 以前の 居者 院 • 2011年以降, 推定死亡率は7 で10.4%, 2週 で 13.3%, 1ヶ で18.1%, 3カ で27.0%, 1年 で 30.2% • 2001年以前と 較すると死亡率は低下傾向2) • 死亡リスクは, 敗 症性ショック (OR 4.14), MRSA (OR 4.00), 初期治療の遅れ (OR 2.79)1) 目 1. Clin Microbiol Infect. 2012;18(9):862-869. 2. Clin Microbiol Infect. 2022;28(8):1076-1084. 目 目 月 目 血 目 比 月 用 入 入 入 糖尿病 日 市中発症 心 入 長 入 SABの死亡率
#79.
• 臨床的に5つの病型に分類することが提案されている1) A. 齢かつ合併症を有する患者のSAB B. 合併症のない若い患者の院内発症カテーテル関連SAB C. 転移感染巣を有するSAB D. 慢性腎不全患者のSAB E. 違法静注薬物使 者のSAB • 84-day mortalityはAが最も • 微 • ARREST trial2)の副次解析でRFP追加によりBは死亡率が上昇, Cは微 物学的転機が改善 く, BとEが低い 物学的転機はCが最も悪い 生 高 用 1. Clin Infect Dis. Published online June 25, 2024. doi:10.1093/cid/ciae338 2. Lancet. 2018;391(10121):668-678. 生 高 SABの病型による亜分類
#80.
• VCMをMSSA-IEに対する経験的治療に いた場合, βラクタムと 較し死亡率が4倍に上 昇する1) → 理論上SABの経験的治療はVCMとβラクタムの併 が有 と報告されている2) • , IEが4〜11%含まれるMSSABの患者群に対して, 経験的にVCMを投与しても, βラ クタムと 較し死亡率は上昇しなかったという報告もある3-4) • 個 的には, IEリスクが えている ければVCMとCEZの併 は妥当だが, ルーチンでは不要だと考 1. Antimicrob Agents Chemother. 2007;51:3731-3733. 2. Clin Infect Dis. 2013;57:1760-1765. 3. Clin Infect Dis. 2015;61:361-367. 用 用 比 用 用 用 高 比 方 4. BMC Infect Dis. 2016;16:224. 人 一 SABに対する経験的抗菌薬併 療法
SABの合併症とそのリスク評価
#81.
に基づく経験的治療 • 液培養からS. aureusが検出された際, real time PCRを いてmecA遺伝 運 を導 する前後で, targeted therapyに る時間は変わらず1) • 「mecA陰性であるため, 抗MRSA薬の投与は中 しCEZに変更できる」「mecA陽性であ るため抗MRSA薬が必要である」ということを臨床へ伝えるシステムが必要であると結論 づけられている を同定する 子 用 止 至 子 入 1. J Clin Microbiol. 2012;50(1):127-133. 用 血 mecA遺伝
#82.
液培養陽性分離株はMSSAと同定された →セファゾリン単剤へ変更 日 血 症例-第3病 -
#83.
未だに解熱せず。 • 第2, 4病 • 4 の経胸壁エコーでは弁の異常は報告されず, 理学所 的に明らかではなかった。 液培養を採取し, すべてMSSAが陽性だった。 見 に 日 血 • 日 目 日 症例-第5病 - では他の感染の転移巣は臨床
#84.
間持続菌 症が じており, 解熱していない。 エコー検査によるIEの精査が必須である。 生 道 血 と経 心 々の理学所 日 • 本症例は少なくとも5 食 • 見 日 追加精査
#85.
液培養をフォローするか? つまり, 初回の 液培養のタイミングを決定するために, どの程度SABが続くと, 合併症 の可能性が上がり, 診療 針や患者予後に影響がでうるかを知る必要がある。 血 じている可能性を 積もるために, 見 生 • 血 管内感染症 (IEなど) の合併や, 播種感染巣が 液培養陰性化確認が必要である。 方 • 血 血 なぜ・いつ
#86.
なぜ・いつ 液培養をフォローするか? 菌 • IE合併リスクも死亡率も, SABが2-3 上昇する1-4) • 播種感染などの合併症有病率は, SABが1-2 間続いた場合6.6%だが, 3 間続くと24%に 上昇する5) → 培再検は2 後, 遅くとも3 1. 2. 3. 4. 続くと 後が良い Clin Infect Dis. 2015;61:18-28. J Infect. 2016;72:544-553. Lancet Infect Dis. 2020;20:1409-1417. Clin Infect Dis. 2020;70:566-573. 日 日 日 血 日 日 血 血 5. Scand J Infect Dis. 2006;38:7-14. 症の期間が異なる患者のKM survival curve3)
#87.
SABの 培陰性確認は1回で良いか? • SABの5-10%程度で間 的 • Day 1-3で 培フォローした場合の間 的陰性発 に対する陰性的中率は87-93%だが, Day 4以降であれば95%となり, 持続菌 症を 逃す可能性は下がる2) • 個 液培養陰性が じる1-2) 的には, 患者が低リスクで経過に問題なければ陰性確認は1回でよいと思っている 生 見 生 血 欠 血 欠 血 血 人 1. Pediatrics. 2020;146(6):e20201821. 2. Open Forum Infect Dis. 2019;6(12):ofz494.
#88.
• • • • 道 エコーの適応は? い換えれば, 本症例にどれくらいIEの可能性があるか?ということ SAB患者全体におけるIEの頻度は12%1) 然弁IEの検出に関する感度/特異度は, TTE 75%/90%, TEE 96%/90%2) - 機械弁での検出感度はTTE 50%, TEE 92%2) 弁輪部膿瘍の検出感度はTEE 87%程度3) 持続菌 症や合併症の有無により, IEリスクを 積もる必要がある 見 心 血 1. Arch Intern Med. 2003;163(17):2066-2072. 2. Eur Heart J. 2015;36(44):3075-3128. 3. Heart. 2004;90(6):614–7. 食 自 言 経
#89.
1. 恒久的 内デバイスが無い 2. 最初の 液培養陽性から4 以内のにフォロー 培で陰性化する 3. 透析していない 4. 院内発症である 5. 次転移巣の証拠がない 6. IEの徴候がない → 上記全てが当てはまれば, IEの陰性適中率93-100% 門 血 日 血 JAMA. 2014;312(13):1330-1341. 心 二 IE低リスク群は狭き
#90.
PREDICT study - Day 1…CIED (ICD 2pt, PPM 3pt, なし 0pt), Onset (市中 2pt, 医療福祉施設 1pt, 院内 0pt) → 0-5 pt → ≧ 4 ptならば感度30.4%, 特異度93.8% - Day 5…CIED (ICD 2pt, PPM 3pt, なし 0pt), Onset (市中 2pt, 医療福祉施設 1pt, 院内 0pt), 持続菌 症 (≧72h 2pt) → 0-7 pt → ≦ 2 ptならば感度, 陰性適中率100% SAB発症から5 の時点で, 下記を満たせばIEではない (有病率13%の集団で98.5%の精度) (1)CIEDなし (2)市中発症ではない 症(≧72時間)ではない (3)持続菌 目 日 Clin Infect Dis. 2015;61:18-28. Clin Infect Dis. 2021;73(7):e1745-e1753. 血 • Day 1 ≧ 4pts → , Day 5 ≦ 2pts (IEリスクを, SAB発症からDay 1とDay 5で2回評価) 血 •
SABの治療におけるバンドル管理
#91.
• PREDICT研究の前向きvalidation study2) • 220 がスクリーニングされ, 199 のSABが 参加 (23 [11.6%] が修正Duke基準により de nite IE) • Day 1のスコア ≧4 → 感度30.4%, 特異度 93.8%。 • Day 5のスコア ≦2 → 感度, 陰性適中率は 100% • 弁 , 過去30 以内のope, 培陽性本数 が多いことは, day5のスコアに関連なくIEリ スク 人 血 日 人 心 人 fi 1. Clin Infect Dis. 2015;61:18-28. 2. Clin Infect Dis. 2021;73(7):e1745-e1753. 工 人 PREDICTのアルゴリズム1)
#92.
VIRSTA score 項 Pts 脳・末梢塞栓 5 髄膜炎 5 IE既往or 内デバイス埋め込み 弁膜症 3 静注薬物使 持続菌 敗 4 これらの項 があると IEを否定できない 4 症 3 脊椎椎体炎 2 市中発症 2 症性ショック 1 CRP>19mg/dl 1 合計が≦2点であれば 有病率11%の集団で IEの陰性適中率98.8% 目 用 心 血 目 血 J Infect. 2016;72:544-553.
#93.
• • validation studyでは, 6.7%がIEの集団で, VIRSTA陰性の場合IEの頻度は0.44% VIRSTAスケールの感度は96.7%、陰性予測値(NPV)は99.5% Clin Infect Dis. 2021;73(5):e1151-e1157.
#94.
陽性時間 (TTP) <9時間 5点 TTP 9-11時間 3点 TTP 11-13時間 2点 IV drug使 中 3点 管現象* 基礎 6点 疾患 5点 血 比 非 血 ff 血 用 足 ff ’ 手 *動脈塞栓, 敗 症性肺塞栓, 感染瘤, 頭蓋内出 結膜や の出 斑 心 血 POSITIVE score • Duke s基準で定義されたIEの有病率8.2%の集団に対 して, cut o >4点と設定すると感度93%,特異度 70% • IE患者では, IEと 較しTTPが短かった (8.7時間 IQR [7.7-10.6] vs 13.3時間 IQR [10.5-16.5]) • cut-o を13時間に設定すると, 感度100%, 特異度 52% , Clin Microbiol Infect. 2021;27(9):1345.e7-1345.e12.
#95.
スコア 感度 (%, 95%CI) スコア POSITIVE 特異度 (%, 95%CI) 較 陰性適中率 (%, 95%CI) 陽性適中率 (%, 95%CI) AUC 77.6 (65.8–86.9) 63.1 (57.3–68.6) 92.5 (87.9–95.8) 32.3 (25.1–40.1) 77.8 (71.9–83.7) PREDICT day 1 22.9 (14.6–33.5) 97.4 (95.3–98.8) 85.0 (81.4–88.2) 66.7 (47.2–82.7) 71.4 (65.2–77.5) PREDICT day 5 85.1 (75.8–91.8) 56.9 (51.8–61.9) 94.5 (90.7–97.0) 30.5 (24.7–36.8) 79.7 (73.9–85.4) a VIRSTA 98.9 (95.7–100) 35.7 (30.8–40.6) 99.3 (94.9–100) • カットオフはPOSITVE >4, PREDICT ≥2, VIRSTA ≥3 • VIRSTAが最も感度が • PREDICT Day 1は特異度が最も 25.5 (20.7–30.3) 88.9 (85.3–92.5) く, NPV 99.3% く,TEEを早期に うべき患者の検出が可能 行 高 高 比 Clin Infect Dis. 2022;74(8):1442-1449.
#96.
- 臓内埋め込みデバイス 持続菌 症 塞栓症状 髄膜炎など中枢症状 IEの既往 基礎弁膜症 行 上記があればTEEは早期に うべきだが, ない場合はcase by caseで適応を判断していくし かない 血 心 スコアまとめ
#97.
つけるか? • 以下の場合はTEEでも疣腫が つかりにくく, 疑わしくば5-7 (1) 弁や重症MVP, 灰化がある (2) 2-3mm未満の疣贅 (3) 既に疣腫が んでいる • リスクSABに対する7-14 のPET-CTは, 転移感染巣を つけるのに役 ち, 90 死 亡率低下に関連する可能性があり2), 欧州におけるアンケート調査で, SABの治療期間決 定のため約50%がPET-CTを なっていると解答3) • 実臨床では, 々の診察と間隔をあけて疑わしい部位の画像検査・エコーを繰り返すしか ない 例:椎間板炎のMRI所 は症状出現から10 間程度遅れる4) 1. Eur Heart J. 2015;36(44):3075-3128. 後の再検が推奨される1) 日 立 日 見 見 日 目 見 行 日 見 石 日 飛 工 2. Clin Infect Dis. 2021;73(11):e3859-e3866. 3. J Antimicrob Chemother. 2022;77(10):2827-2834. 4. BMC Musculoskelet Disord. 2020;21(1):428. 人 高 転移感染巣をいかに
#98.
経 道 された エコーが • 持続菌 症が治まっておらず, 管外科による 行 臓 手 血 われ, 僧帽弁に可動性を有する10mmのvegetationを認め, IEと診断 心 日 • 行 心 血 食 症例-第7病 - 術を なわれた。
#99.
SABの治療期間 •Uncomplicated:≧14 日 日 •Complicated:≧28
#100.
1. 抗菌薬開始後48-72時間以内にSABがclearanceされ, 臨床症状が改善する 2. 感染巣が除去可能である 3. 転移感染巣が無い 4. 管内異物がない (eg, prosthetic valves, cardiac devices, vascular grafts) 5. エコーで 内膜炎が否定されていること Am J Med. 2023;136(1):19-26. 100 心 心 血 uncomplicated SABの定義
SAB管理のためのQuality Indicators
#101.
• - 複雑性SABの治療期間を評価した前向きコホート研究@韓国 複雑性の定義:2-4 の 液培養フォローが陰性, 治療72時間以内に解熱, 播種感 染巣なし, エコーでIEがないCRBSI or 原発性菌 症 • SABの483名の患者のうち, 111名 (23.0%) が • <14 (38名) vs ≧14 (73名) - 治療失敗率 (26.3% vs 21.9%) → 有意差なし - 死亡率 (18.4% vs 21.9%) → 有意差なし - 再発 (7.9% vs 0.0%) → 有意に増加 • 多変量解析では, 原発性菌 症は治療失敗が増える傾向にあり, CRBSIなどの 複雑性 SABでなければ めの が良さそう 複雑性SAB (MRSA 53例 [47.7%]) 非 血 非 血 血 目 日 方 日 長 心 Antimicrob Agents Chemother. 2013;57(3):1150-1156. 日 非 非 SABの治療期間
#102.
• SABの治療期間(DOT)と死亡率・再燃を評価した単施設後 視的コホート研究@スイス - SAB 530 中, MRSA 17.7%, 複雑性 57.6% 物埋め込み, 2 以上菌 症が持続, 3 以上の発熱 - 複雑性の定義:IE, • 全体の90 • 複雑性SABの死亡率はDOT >14で有意に低下 (aHR 0.32, 95% CI 0.16-0.64) したが, 複雑性SABの死亡率/再発はDOTと関連なし (それぞれ0.85;0.41-1.78, 1.01;0.971.06) • コホート全体で90 以内に死亡した患者は, 感染症医の診察や 有意に低かった (29.3% vs 15.8%) 死亡率 27.0% (143/530), 再発 3.4%(18/530) エコーを受ける可能性が 心 日 方 血 日 工 人 日 日 Clin Microbiol Infect. 2020;26(5):626-631. 人 非 SABの治療期間
#103.
SABの治療期間 • 3つの後 視的研究のSR • Long (>14; >18; 11-16 days) vs. short (≤14; 10-18; 6-10 days) で90 差は無し 死亡率に 日 方 Clin Microbiol Infect. 2024;30(10):1254-1260.
#104.
SABの管理と死亡率 • SABの管理と死亡率との関係を評価した後 視的研究 • 以下が死亡率低下に有意に関連 - 適切な抗菌薬投与 (aOR 0.74) - エコー施 - 感染症医へのコンサルト (aOR 0.61) (aOR 0.73) 方 行 JAMA Intern Med. 2017;177(10):1489-1497.
#105.
バンドル管理 • Quality of Care Indicators (QCIs) 遵守と30 係を後 視的に検討@ 本 死亡率の関 • 2006-2014年に診断されたSAB477症例を対象 (MRSA 41.7%) • QCIs:① 液培養フォロー, ②早期の感染巣コントロール, ③ エコー, ④適切な抗菌薬の早期使 , ⑤適切な治療期間 • QCIs≧4の割合は2006→2014年で47.5%→79.3%に増加 し, 30 死亡率は10.0%→3.4%へ低下 • バンドル管理は, SABの死亡率を下げる QCIsに基づくSAB患者の予測死亡率 日 用 日 血 方 日 心 Infection. 2017;45(1):83-91.
#106.
アルゴリズム治療 • Staphylococcus菌 症をアルゴリズムに基づき分類・治療する群と, 臨床医判断に委ねる群とで 治癒率や有害事象の複合転機をみたRCT (23%がSAB) • Uncomplicated SAB:14 治療 - 感染巣になっているカテーテルを5 以内に抜去, 24-72時間後の初回 液培養フォローが陰 性, 72時間以内の解熱, エコーでIEが否定的, 転移感染巣がない • Complicated SAB:28〜42 治療 - 持続菌 症, 持続発熱, IE, 転移感染巣がある • 当初uncomplicatedと分類されたSABの1/3が途中complicatedだったと判明 • 治癒率 (アルゴリズム vs UC): 血 日 日 日 心 Uncomplicated 70.6% vs 75.6%, Complicated 82.6% vs 35.7% 血 血 - JAMA. 2018;320(12):1249-1258.
#107.
SAB管理@MD Anderson https://www.mdanderson.org/content/dam/mdanderson/documents/for-physicians/algorithms/clinical-management/clin-management-saureus-bacteremia-web-algorithm.pdf (accessed October 13, 2024)
#108.
SAB管理のレビュー Am J Med. 2023;136(1):19-26.
#109.
Blood cultures Quality indicators De ning condition 1. 抗菌薬療法開始後のfollow-up 液培養は, 臨床的 抗菌薬療法開始後の最初のフォローアップ 改善にかかわらず実施すべきである。 得る最適な時期は48時間後である。 2. 再 液培養の採取は、最初に るまで実施すべきである 液培養が陰性にな 液培養を 液培養再検の適切なタイミングは48時間後である。 血 血 血 fi J Antimicrob Chemother. 2019;74(11):3344-3351. 血 血 SAB管理のためのQuality Indicator
#110.
Echocardiography Quality indicators De ning condition IEの素因となる 疾患を有するSAB患者においてTTE 3. TTEは, IEの素因となる 疾患を有する患者におい を実施する最適な時期は3-5 時点で, 14 以降にす て実施されるべき (TEEを先に う場合は不要) ることは望ましくない。 4. SABの合併症のリスクを有する患者ではTTEを実 施すべきである。 SABの合併症のリスクを有する患者においてTTEを実 施する最適な時期は3-5 時点で, 14 以降にするこ とは望ましくない。 5. 合併症を伴うSABと診断された患者にはTTEを実 施すべきである。 complicated SAB患者においてTTEはなるべく早く, 培陽性後72時間以内に う。 • • SABの合併症リスク: 市中感染, 適切な治療開始48時間以上前の感染徴候, 適切な治療開始72時間以上後の発熱, 適切な治療開始48時間以上後の 液培養陽性。 合併症のない菌 症: 内膜炎や他の転移性感染部位の除外, implanted prosthesesの 如, 液培養を再検査した患者の4 以内の菌 症の排除, 効果的な治療 開始後72時間以内の解熱。複雑性菌 症: 単純性菌 症の基準に該当しない場合。 血 血 日 血 欠 日 日 血 行 日 行 血 日 心 心 心 血 J Antimicrob Chemother. 2019;74(11):3344-3351. fi 血 SAB管理のためのQuality Indicator
SABの死亡率と管理のまとめ
#111.
Echocardiography Quality indicators De ning condition 6. TEEは, IEの素因となる 疾患を有するSAB患者に IEの素因となる 疾患を有するSAB患者においてTEE おいて実施されるべきである。 を実施する最適な時期は3-5 時点で, 14 以降にす ることは望ましくない。 SABの合併症のリスクを有する患者においてTEEを実 7. SABの合併症リスクを有する患者ではTEEを実施す 施する最適な時期は3-5 時点で, 14 以降にするこ べきである。 とは望ましくない。 8. 合併症を伴うSABと診断された患者にはTEEを実施 complicated SAB患者においてTEEはなるべく早く, すべきである。 培陽性後72時間以内に う。 • • SABの合併症リスク: 市中感染, 適切な治療開始48時間以上前の感染徴候, 適切な治療開始72時間以上後の発熱, 適切な治療開始48時間以上後の 液培養陽性。 合併症のない菌 症: 内膜炎や他の転移性感染部位の除外, implanted prosthesesの 如, 液培養を再検査した患者の4 以内の菌 症の排除, 効果的な治療 開始後72時間以内の解熱。複雑性菌 症: 単純性菌 症の基準に該当しない場合。 血 血 日 血 欠 日 日 血 日 行 血 日 心 心 心 血 J Antimicrob Chemother. 2019;74(11):3344-3351. fi 血 SAB管理のためのQuality Indicator
#112.
SAB管理のためのQuality Indicator Non-antibiotic therapeutic interventions Quality indicators 9. SABと診断された後, する De ning condition 管内カテーテルを必ず抜去 SAB診断後 管内カテーテルは直ちに抜去すべきだが, 少なくとも24時間以内がよい。 10.SAB患者においてCIEDに感染が認められた場合, それらを抜去するべきである。 11.SAB患者において 関節が感染している場合, デ ブリドマンと/または外科的抜去を うべきであ る。 12.SAB患者における膿瘍はドレナージするべき SAB患者におけるドレナージの時期は24時間以内が望 ましい。 行 血 工 人 血 fi J Antimicrob Chemother. 2019;74(11):3344-3351.
#113.
SAB管理のためのQuality Indicator Antibiotic treatment Quality indicators 13.SAB患者の初期抗菌薬は経静脈的に投与されるべきである。 14.SAB患者においてメチシリン感受性株の場合は初期治療は経静脈的( u)cloxacillin (or nafcillin or oxacillin) またはcefazolinとするべきである 15.抗菌薬治療は最初の 液培養陽性から24時間以内に開始するべき。 16.必要であれば, メチシリン感受性の結果が得られてから24時間以内に適切な治療を適応すべきである。 17.SAB患者の抗菌薬投与量は (国際的) ガイドラインに基づくべき。 18.uncomplicated SABにおける適切な経静脈的抗菌薬投与期間は少なくとも14 であるべき。 日 fl 血 J Antimicrob Chemother. 2019;74(11):3344-3351.
#114.
SAB管理のためのQuality Indicator Antibiotic treatment Quality indicators 19.抗 物質の静脈内投与の適切な期間は, 転移性膿瘍または深部感染巣を合併したSABでは少なくとも28 間であるべきである (IEを除く) 20.バンコマイシンで治療されているSABは治療薬モニタリングを受けるべき。 21.SAB患者の抗菌薬治療量は腎機能に合わせるべき。 22.uncomplicated SABにおいて, 48–72時間後でも経 23.complicated SABにおいて、48–72時間後でも経 切り替えを うべきではない。 切り替えを うべきではない。 Other management aspects Quality indicators 24.SAB患者では感染症専 医へのコンサルトを うべき。 25.SABは退院時要約に記録すべきである。 日 行 行 口 口 行 門 生 J Antimicrob Chemother. 2019;74(11):3344-3351.
#115.